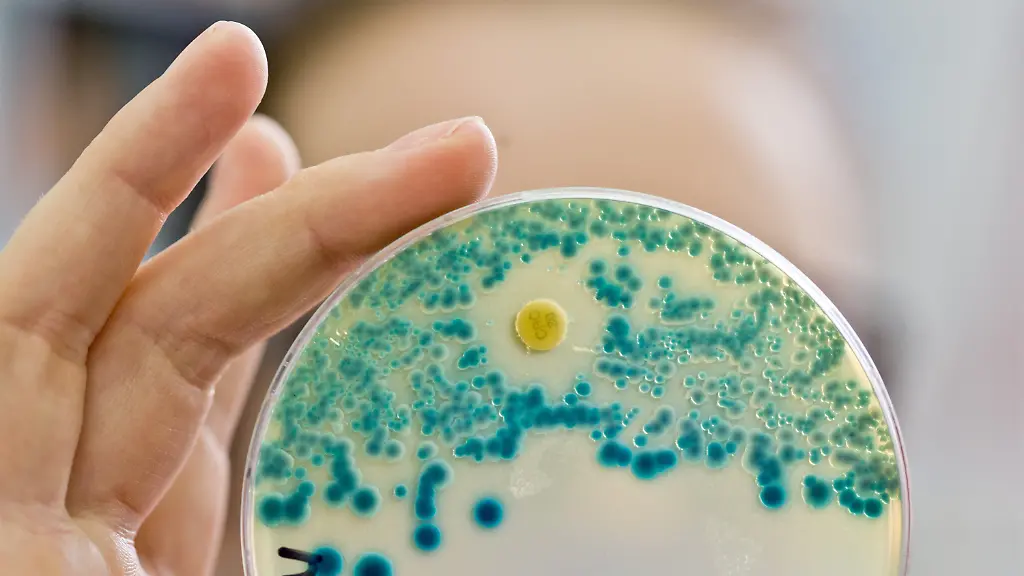
6ef7dd76144e9b5330033b0f3433cc55

Antibiotika-Resistenz wächstWHO präsentiert Liste der "Killer-Keime"
Gegen resistente Bakterien haben herkömmliche Medikamente keine Chance. Die WHO stellt nun eine Liste der größten Bedrohungen auf. Zwölf Bakterienfamilien sollen Pharmaforscher ins Visier nehmen.
Wenn Antibiotika nicht mehr anschlagen, sind Ärzte machtlos und Patienten ihrem Schicksal ausgeliefert. Schuld sind Bakterien, die gegen alle verfügbaren Medikamente resistent geworden sind. Die Weltgesundheitsorganisation (WHO) ist alarmiert. Jetzt hat sie erstmals eine Liste mit den zwölf für die Menschheit gefährlichsten Bakterienfamilien veröffentlicht. Sie rief Regierungen in Genf auf, Anreize für Forscher in Universitäten und Pharmafirmen zu schaffen, um neue Antibiotika zu entwickeln.
Betroffen seien Millionen Patienten in aller Welt, sagte Evelina Tacconelli, Mitglied der Europäischen Gesellschaft für klinische Mikrobiologie und Infektionskrankheiten (ESCMID). 60 Prozent der Patienten mit schweren Infektionen, die sich nicht mit Antibiotika behandeln lassen, sterben nach ihren Angaben. An Schätzungen über die weltweite Zahl von tödlichen Infektionen durch Antibiotika-resistente Bakterien wolle die WHO sich aber nicht beteiligen.
Resistente Erreger müssen global bekämpft werden
Britische Forscher nannten 2014 eine Zahl von weltweit 700.000 im Jahr. Die WHO entwickelte die Liste mit Forschern der Universität Tübingen. Das Thema soll bei einem G20-Treffen von Gesundheitsexperten nächste Woche in Berlin zur Sprache kommen. "Wir brauchen heute und in Zukunft wirksame Antibiotika, um übertragbare Krankheiten gut behandeln zu können", sagte Bundesgesundheitsminister Hermann Gröhe. "Mit der Deutschen Antibiotika-Resistenzstrategie gehen wir im Kampf gegen Antibiotika-Resistenzen voran." Krankheiten und resistente Erreger würden keine Grenzen kennen und müssten global bekämpft werden.
"Die Antibiotika-Resistenz wächst, und wir haben bald keine Behandlungsmöglichkeiten mehr", sagte WHO-Expertin Marie-Paule Kieny. "Wenn wir es allein den Marktkräften überlassen, werden die neuen Antibiotika nicht rechtzeitig entwickelt." Die Liste enthalte bewusst nicht die Tuberkulose-Erreger, weil die Entwicklung neuer Medikamente dafür bereits im Gange sei.
Nach WHO-Angaben entwickeln allein 480.000 Menschen im Jahr eine Resistenz gegen Anti-Tuberkulose-Mittel. Besonders gefährlich seien Keime, die gegen mehrere Antibiotika resistent sind, so die WHO. Diese Bakterien veränderten sich ständig und werden so auch gegen neue Medikamente immun. Diese Immunität könnten sie auch an andere Bakterien weitergeben. Zu den Gattungen der gefährlichsten Keime gehören laut WHO etwa Acinetobacter, Pseudomonas und Enterobacter. Zu Letzteren gehören Kolibakterien, die Durchfälle auslösen können.
Ältere Menschen sind besonders infektionsanfällig
"Wir wollen jetzt keine Panik über neue Supererreger verbreiten", sagte Kieny. "Es geht darum, die Forschungsanstrengungen zu fokussieren." Anreize könnten etwa Prämien für Pharmafirmen sein, wenn ihr Medikament auf den Markt kommt.
Neben Transplantations- und Chemotherapiepatienten sowie Kranken, die Katheter haben oder beatmet werden müssen, seien Bewohner von Pflegeheimen besonders betroffen, sagte ESCMID-Mitglied Tacconelli. Problem dort sei unter anderem "der unkontrollierte Einsatz von Antibiotika". Nicht immer sei ein Arzt vor Ort und Bewohner bekämen teils Antibiotika, wenn es nicht nötig sei. Das führt dazu, dass umso mehr Erreger resistent werden. Ältere Menschen hätten oft ein geschwächtes Immunsystem und seien infektionsanfällig.